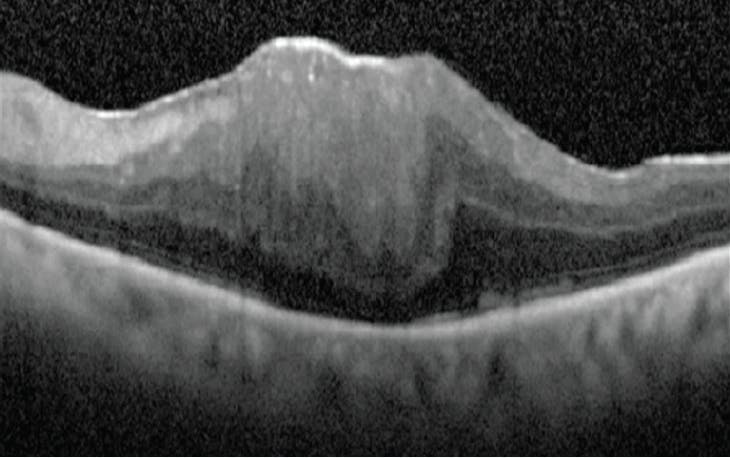

Introduction and Objectives
Vitreous opacities or floaters are a common ocular condition that seem ubiquitous in a retina practice. Although symptoms are minimal in most patients, they can cause significant impairment in vision-related quality of life (QoL) in some patients. Awareness of the visual disability caused by floaters and the evidence base for treatment of this condition using small-gauge vitrectomy has increased.1 Still, selection of appropriate patients for surgery is often difficult because of the relative lack of objective findings and outcomes with which to measure both visual impairment and improvement post-procedure.2 Although there are no official guidelines on when vitrectomy should be considered, the faculty panel has rules they adhere to when managing patients with vitreous opacities. The objectives for this panel discussion included: providing an overview of symptomatic vitreous opacities and their treatment options, discussing best practices in patient identification for surgical treatment, reviewing surgical pearls for vitrectomies and the role of laser treatment, if any at present, and providing clarity around the treatment approach to optimize outcomes for patients with vitreous opacities.
A Common Issue
Floaters or vitreous opacities are one of the most common, albeit least treated, ocular conditions.1 Symptomatic vitreous opacities are floaters that are bothersome enough to motivate a patient to seek relief. Very few studies have been conducted to assess the incidence and prevalence of vitreous opacities. A Swedish study estimated the incidence of symptomatic vitreous opacities requiring pars plana vitrectomy (PPV) as 3.1/100,000 per year based on a patient cohort that presented over a 9-year period.3 An international study evaluated the prevalence of floaters in a community sample of smartphone users. Out of a total of 603 individuals from the United States, Australia, Israel, and United Kingdom who completed this electronic survey, 76% reported floaters and 33% found them to be causing visual impairment.4 The most common cause of vitreous opacities is posterior vitreous detachment (PVD). Risk is also associated with increasing age, myopia, retinal tear, retinal detachment (RD), intraocular inflammation, vitreous hemorrhage, and trauma. Recent eye surgery can increase the perception of floaters.5,6
Although symptoms are minimal in most patients, vitreous opacities can cause significant impairment in vision-related QoL in some patients. In a cross-sectional questionnaire study (N = 266), the negative impact of floaters on QoL was comparable to that of other eye diseases such as age-related macular degeneration (AMD) and diabetic retinopathy as well as systemic diseases like mild stroke, colon cancer, and asymptomatic HIV infection. Patients in this study were willing to take an 11% risk of death and 7% risk of blindness to eliminate floater symptoms, underscoring the toll that floaters can have on patients’ lives. Younger symptomatic patients (21-55 years) were more likely to risk blindness to get rid of vitreous opacities than older patients (>55 years).7
It is objectively difficult to quantify the degree of impairment caused by vitreous opacities. Snellen acuity does not quantify visual disability caused by floaters on daily functioning or overall QoL.7 Medicine is an applied science, and its practice is an art, which involves individualizing approaches to specific patients using judgment of different floater and personality types.
Edwin Ryan, MD, recommends imaging with the Heidelberg Engineering 6-mode scanning laser ophthalmoscopy (SLO) in “MovieMax” which records the SLO as a video and preferably with a 55° lens for better visualization. The patient will fixate at the blue light in the center then do two saccades to the left and two saccades to the right with 3 seconds between the saccades for optimal imaging of the motion of the opacities. This indirect imaging is from infrared laser shadowing, so the dark image is not the floater but the retina where the shadow is projected by the floater. Dr. Ryan compares SLO imaging to infrared maps of clouds from outer space on the National Weather Service forecasts. It is a great tool because it provides an image to discuss with patients. Patients often feel vindicated by the image, which also helps a patient’s spouse/family understand what the patient has been dealing with. On the other hand, if the image does not show floaters to the degree that a patient has been describing, it helps Dr. Ryan decide if the risks of surgery are too great and if additional waiting is warranted; he then decides whether to persuade patients to accept that advice. John Kitchens, MD, and Tarek Hassan, MD, noted that static OCT does not project floaters the way surgeons need it to in order to understand a patient’s symptoms and that SLO is a better option to see the clouds in the anterior vitreous.
Treatment Approaches
Current approaches to vitreous opacities include observation, PPV, and Yttrium Aluminum Garnet (YAG) laser vitreolysis. Management considerations are based on patient complaints, symptoms, and exam findings.
Observation
The starting point for the vast majority of patients is observation. In acutely symptomatic patients, generally at the onset of PVD, symptoms are commonly transient and/or become easily tolerable in most cases.1 Most patients with mild floaters learn to ignore them through neuroadaptation.8 Reassurance that the floaters have been evaluated and raise no threat to vision can be very helpful. For example, Edwin Ryan, MD, had a patient, who was a commercial airline pilot, travel from the Middle East to Minnesota to have his vitreous opacities evaluated. Although Dr. Ryan concluded that observation was the right approach, the patient was relieved and accepted the plan even after travelling so extensively for the visit. If a patient complains of floaters which cannot be visualized on clinical exam, the need for surgery is typically questioned. On the other hand, some patients have prominent vitreous opacities visible on examination, but have minimal or no symptoms. Both of these groups of patients are generally observed without intervention.6
S. K. Steven Houston III, MD, commented that each surgeon must develop their own criteria and, ultimately, stick to their comfort level regarding patient selection. His standard approach to patients with symptomatic floaters includes:
Consultation With Patient With Floater Complaints
- Obtain history to determine if acute or chronic
- If chronic and there is no other pathology to explain symptoms, discuss vitrectomy
Required Patient Criteria
- Posterior vitreous detachment confirmed on exam/OCT
- Symptomatic for ≥6 months
- Pseudophakic; however, if a patient is phakic and has some cataract, Dr. Houston will refer the patient for cataract extraction. Some patients are happy after cataract surgery and do not need to deal with floaters, others may then consider vitrectomy
- If no capsulotomy, then he will open the capsule during surgery
Surgical Procedure
- 25- or 27-gauge procedure
- Core vitrectomy* with non-aggressive peripheral shaving
- Open posterior capsule, if not already open
- Scleral depression (one of the most important steps of the procedure) and laser anything suspicious
- Air-fluid exchange
With this Strict Criteria and Surgical Approach, the Risks are Very Low:
- Retinal detachment risk is less than 0.5%
- Rate of epiretinal membrane development or progression of epiretinal membrane to need surgery is less than 1%
*Dr. Houston tends to perform vitrectomy on the most symptomatic eye first, if both eyes are affected. He will wait for 4 weeks in between, make sure the patient is happy, and confirm there are no IOP issues or other complications. After about a week most patients are eager to have the other eye done.
Dr. Houston noticed that 30-40% of floater cases in his practice have multifocal IOLs, which seem to exacerbate the symptoms of floaters. Dr. Ryan commented that the typical multifocal patients in his practice are high functioning individuals with high expectations. Such patients will demand the best possible vision and may be a little more inclined to proceed to vitrectomy for vitreous opacities.
Vitrectomy
Vitrectomy for vitreous opacities was considered taboo until 2000, when clinical results were published describing positive patient outcomes.9 Now, vitrectomy is the most common surgical intervention for vitreous opacities.10 There are no guidelines for vitrectomy for vitreous opacities; however, the procedure is generally reserved for patients whose symptoms are persistent and result in significant visual disturbance over a prolonged period of time.2 The use of smaller gauge surgical incisions has improved safety,2 and studies support improved QoL after vitrectomy.1,3,9 There remains, however, a small risk of significant vision loss.1,2,6 Surgical risks include: cataract formation, retinal tear and detachment, macular pucker, macular edema, endophthalmitis, and epiretinal membrane (ERM).
Benefits of vitrectomy for vitreous opacities include improved reading speed and contrast sensitivity. In a study using the vision test app MNREAD to assess changes in reading ability post-vitrectomy for symptomatic vitreous opacities, maximum reading speed increased from 138 to 159 words per minute post-surgery (P < .001)
Visual Function Questionnaire (VFQ)-25 scores improved 26% on average following vitrectomy.11 For context, VFQ-25 score improvement in the ANCHOR and MARINA phase 3 AMD clinical trials averaged around 7%.12 In a long-term case series study evaluating the safety and efficacy of vitrectomy for vision degrading vitreopathy resulting from vitreous floaters, preoperative contrast sensitivity function was degraded by 91.3% compared with controls (P < .0001), normalizing after surgery.13
YAG laser vitreolysis
YAG laser vitreolysis for vitreous opacities is increasingly being utilized by a small number of ophthalmologists. It is generally considered most suitable for Weiss rings and few discreet floaters, whereas >3 floaters or more peripheral lesions have been considered less amenable to laser vitreolysis.2 Since research and clinical experience remain limited, more long-term efficacy and safety data are needed before widespread adoption.2,14 None of the faculty on this panel have incorporated YAG laser vitreolysis into their practice.
CASE 1: AN INCREASE IN BOTHERSOME FLOATERS FOLLOWING CATARACT SURGERY
BY TAREK HASSAN, MD
Case Background
- A 54-year-old man was eager to address his abrupt onset vitreous opacities
- Three weeks prior to presentation he had cataract extraction (CE) in the left eye and multifocal IOL
- He was initially happy with the results but 2 weeks following CE, he had 1-week history of significant increase in very bothersome floaters
- VA was 20/20 in the right eye and 20/30 in the left eye
- Fundus exam was unremarkable in the right eye; there was no posterior vitreous detachment (PVD). In the left eye, there was PVD with a Weiss ring, no retained lens material, inferior coloboma (Figure 1), and no prior history of retinal tear
- Dr. Hassan told him to monitor his symptoms, anticipate improvement, and return in 6 months. Exactly 6 months to the day later, he returned noting that his symptoms were even worse. He held off on CE in the right eye because he was so unhappy with his overall visual functioning. He was clearly visually disabled and wanted something done about the floaters in the left eye

Figure 1. Inferior coloboma in the left eye of a patient presenting for his abrupt onset vitreous opacities.
Why Do Similar Floaters Bother Some Patients and Not Others?
When Dr. Hassan considers vitrectomy for floaters, it is imperative that he understands the anatomy of what causes a patient’s floater symptoms. This allows him to become as convinced as possible that the patient’s complaints are indeed explained by the vitreous opacities and will best be solved with vitrectomy. There are multiple factors that make symptoms intolerable including:
- Size
- Shape
- Density
- Movement: Some move further out of the visual axis, at different speeds, and some are tethered to epiretinal membrane tissue, the optic nerve, old peripheral retinal pathology, etc.
- Coexistent pathology: Often under-considered, most patients with symptomatic floaters have other issues that may be contributing to the exacerbation of their symptoms, such as myopia or dry eye disease
- IOL status: With multifocal IOLs, the optics probably make floaters more annoying. When IOLs are slightly decentered, floaters can be more bothersome as they move in and out of different focal planes
- Completeness of PVD: Many people have parts of the vitreous separation that are not complete, and if that happens close to the visual axis, IOL, or macula, floaters will be more symptomatic
- Asteroid hyalosis (AH): Symptoms can suddenly worsen despite having AH for years, if there is an evolving PVD
Procedure
- Dr. Hassan prefers to use 25 gauge because of the flow and efficiency as well as the likelihood of causing less traction on the peripheral retina, which occurs in the setting of less efficient cutting
- Dr. Hassan starts with the anterior hyaloid (Figure 2). The location of the floaters relative to the IOL is extremely important. There can be a lot of opacified vitreous material right behind the IOL. Aside from a tethered PVD, he feels that anterior vitreous opacities tend to be the most symptomatic, particularly in a pseudophakic patient
- He cleared the IOL perimeter and area around the three sclerotomy sites under direct visualization
- He looked to ensure that a complete PVD was created, which included a search for vitreoschisis, which is underrealized in many cases. The patient had a Weiss ring preoperatively, and this was noted at the beginning of surgery. He found the true back edge of the posterior hyaloid; however, after using suction techniques he removed it up to the vitreous base, being highly cognizant of the risk of creating retinal tears when inducing PVDs any further peripherally in this type of patient. He did not think it was necessary to take the PVD all the way out past the posterior vitreous base. He stopped somewhere short of that and effectively removed any issue that exists centrally that would be visually symptomatic to the patient (whether immediately after this vitrectomy or later if a true hyaloidal separation would occur or if the vitreoschisis layer was not removed)

Figure 2. Anterior hyaloid in the left eye of a patient presenting for his abrupt onset vitreous opacities.
Surgical Pearls to Safely Restore Functional Vision
- Remove anterior hyaloid and any dense and visible debris near the IOL
- Separate and remove all of the posterior hyaloid elements particularly out to, but not necessarily involving, the vitreous base
- Incomplete PVDs with floaters are often quite symptomatic—make every attempt to remove all adherent elements
- Look for vitreoschisis; avoid future floaters with separation of hyaloidal elements
- Use small gauge, preferably 25 gauge for now, and possibly 27 gauge in the future with continued improvement in cutting. The vitreous in many of these patients is “sticky” and 27-gauge systems need improved cut rates, aspiration, and overall efficiency to minimize traction before they will be the gauge of choice for such eyes. The 27-gauge HYPERVIT (Alcon) with dual-blade cutter and 20k cut rate has the potential to facilitate the transition from 25 gauge to 27 gauge
- Peripheral depressed exam before closing—look for tears or suspicious areas of thinning like lattice degeneration
- Treat associated pathology (e.g., lattice degeneration)
- Be mindful of patients with symptoms, if associated with AH, multifocal IOLs, or any macular disease. Patients with any geographic atrophy or areas within their central visual field where they have absent vision may be very bothered when their floaters move across the limited functional parts of their retinas accounting for the preponderance of their vision
When Does Surgery Become an Option?
The panel agreed that extensive conversations with patients are necessary to determine when surgery is an appropriate option for vitreous opacities. Dr. Ryan prefers to let the patient do all of the talking with a few open-ended questions. He starts by taking a detailed history of symptoms noting the duration of floaters and whether the onset has been gradual or sudden. Answers to open-ended questions about the impact of floaters on the ability to read, drive, and work provide important perspective as well as the degree of severity—whether floaters are annoying or actually disabling. It must be determined if the symptoms are due to the vitreous opacities or are tied to other conditions, such as cataracts. Following a slit-lamp exam, Dr. Ryan uses OCT to assess for PVD, as well as fundus imaging and video scanning laser ophthalmoscopy for further insights.
If clinical examination reveals vitreous opacities that correlate with symptoms that a patient finds disabling, and there are no other potential causes for the patient’s symptoms, John S. Pollack, MD, noted that he then employs Shared Decision Making (SDM) to make the determination as to whether or not vitrectomy is a reasonable option for the patient. Since the “best” health care choice often depends upon the patient’s own preferences, SDM is particularly valuable when the relative benefits of treatment alternatives depend on a patient’s attitudes toward treatment outcomes, such as exists in the case of symptomatic floaters. SDM is the process through which clinicians and patients work together to make decisions that balance the best available, objective, clinical evidence of risks and benefits with the individual patient’s personal values and preferences.15 Dr. Pollack noted that SDM precedes, and is not the same as, informed consent. Informed consent, on the other hand, represents the final step of the discussion process that represents verification that a patient understands and accepts the potential risks.
Dr. Pollack’s discussion with patients is impacted by a paper by Rahman et al16 on the risk of complications of vitrectomy for floaters. He explains to patients with pre-existing PVD that they have up to ~ 10% chance of developing an intraoperative tear and up to ~ 50% chance, if PVD is induced during surgery. Dr. Houston noted that he usually only performs vitrectomy for patients with symptomatic floaters, if a patient has a complete PVD because of concerns about retinal tears, RDs, ERMs, and cataract. Dr. Pollack stated that, if the floaters are visually disabling and the patient has demonstrated that they understand and accept the potential risks, then he offers patients the option of vitrectomy since development of most complications can be managed should they occur. Christina Y. Weng, MD, MBA, reported that the vast majority of her patients with vitreous opacities are from a PVD but that myopic vitreopathy exists in a significant proportion. If her patients do not have a complete PVD, the floaters may not be as large, but they tend to be tethered to the central visual axis, and they can be very bothersome. Although asteroid hyalosis (AH) is a less common etiology, Dr. Weng has found that when these patients go through a full PVD, they seem to become more symptomatic. Tarek Hassan, MD, agreed and added that AH is an underreported diagnosis that would benefit from vitrectomy.17
After completion of the SDM process, Dr. Pollack will offer vitrectomy, if a patient with disabling floaters strongly desires vitrectomy over observation. He does not believe that YAG laser for floaters currently has strong enough data to support its routine use for management of floaters, but he does inform patients that the technology exists and can be obtained elsewhere. His patients must demonstrate realistic expectations as well as understanding and acceptance of potential risks, including potential persistence of real or perceived floaters. He also informs patients that they need to have the ability and willingness to position with eyes looking down, should that become indicated postoperatively.
Determining the Best Candidates for Surgery
Vitrectomy is a major elective surgical intervention, and one of the key challenges in managing floaters is identifying which patients have significant enough visual disruption to warrant surgery.2 The faculty panel requires that patients with vitreous opacities seeking surgery wait 6 months from their initial consultation before discussing the option further, ensuring the floaters are debilitating enough to justify surgery.
Comorbidities
Dr. Kitchens’ key decision-making principles when considering vitrectomy for vitreous opacities include: Patients have symptoms for ≥6 months, floaters must be debilitating, and ideally, patients are pseudophakic. He has had patients present with symptoms for bothersome floaters with comorbidities such as ERM on the surface of the retina per the OCT. Sometimes there is an ERM that is extrafoveal with a normal foveal contour, and other times, the ERM distorts the foveal contour but VA is still 20/20.
Dr. Kitchens’ approach is to pinpoint any symptoms that can be attributed to the ERM. The patient must have virtually no symptoms consistent with an ERM for him to leave it alone. He then waits a few months, and if it progresses, he will remove the ERM during vitrectomy for floaters. However, if the ERM is static, the patient is asymptomatic, and has VA that is good (20/30 or better), he will leave the membrane alone. Dr. Kitchens has found that eventual ERM removal is required in approximately 10% of his cases. He noted that SDM is very important when discussing such comorbidities. He will show the patient the ERM and explain the potential risks of iatrogenic injury, swelling, atrophy, or permanent disruption to the vision.
It is important to differentiate ocular surface issues. Sometimes patients are confused about their symptoms and will refer to floaters when they really have dry eye. Dr. Kitchens will rule out dry eye by having the patient use drops for a few weeks. The findings of an OCT nerve fiber layer analysis are also key. He makes sure that the nerve does not look suspicious before proceeding with vitrectomy.
In patients with symptomatic ERM, Dr. Kitchens will routinely peel the ERM and internal limiting membrane (ILM) during surgery. Dr. Weng takes a more conservative approach. She discusses mild ERM with her patients and tries to tease out if symptoms stem from the ERM or floaters. She usually prefers leaving the ERM and broaching the possibility of staged surgery with the patient. Dr. Kitchens noted that early on when he did not peel the ILM, there was a 20-25% recurrence of the ERM. Since he has made peeling the ILM routine, there is less than 5% recurrence in his practice. Dr. Ryan agreed and noted it is a common scenario to do ERM surgery with floaters and that the happiest part of surgery for patients is addressing the floaters. Dr. Kitchens noted that amongst patients with comorbidities, those with very limited peripheral vision with floaters impeding their central vision, have done particularly well following vitrectomy.
Comorbidities, particularly macular ones, can be a big deal for patients with vitreous opacities. They only have certain aspects of their macula that function well and when that becomes obscured by floaters, it becomes a real problem. For Dr. Pollack, comorbidities are not an absolute contraindication, but it increases the amount of sleuthing that he will do in order to determine if floaters are the predominant source of the patient’s symptoms. The only scenario where he will absolutely not proceed with vitrectomy for floaters is when he is not convinced that a patient truly understands the risks and potential limitations of surgery. Even in monocular patients, if the floaters are debilitating and the patient understands the risks, he will consider vitrectomy, if this is the clear preference of the patient. Dr. Houston asks monocular patients to keep a daily tally on how often they are affected by floater symptoms for about 6 weeks. That way they can decide if surgery is worth the risks. He has had patients say the floaters are not that bad while others find the impact to be significant, and he will move forward with vitrectomy.
CASE 2: A CASE SHOWCASING RISKS AND COMPLICATIONS
BY CHRISTINA Y. WENG, MD, MBA
Case Background
- A 68-year-old healthy writer with cataracts and floaters for 1 year in both eyes presented stating “they are ruining my life”
- His objective VA was 20/25 in the right eye and 20/20 in the left eye
- Phakic in both eyes with trace nuclear sclerosis
- He had a full posterior vitreous detachment (PVD) in the right eye and partial PVD in the left eye. He had dense vitreous opacities in the anterior vitreous of both eyes and symptoms matched examination; otherwise posterior examination was normal
Approach
- He agreed to wait 6 months to determine if symptoms would spontaneously improve. Dr. Weng explained that, if he remained symptomatic after the 6-month observation, she would offer pars plana vitrectomy (PPV). At the initial visit, she reviewed procedural options of PPV and Yttrium Aluminum Garnet (YAG) vitreolysis and told the patient that she does not recommend the latter due to paucity of data. Six months later, he felt that the floaters were worse and opted for PPV
- Dr. Weng agreed to do PPV in the right eye following extensive discussion of risks including: retinal detachment (RD) or tear, cataract progression, and epiretinal membrane. She does not consider cataract progression to be a complication per se, but notes that many patients will experience progression 1 (about 75% of patients) or 2 years (about 100% of patients) following vitrectomy
- Dr. Weng explained to the patient that there was a possibility he may need a tamponade in his eye, and if so, he wouldn’t be able to fly for a certain period of time and may need to position face-down. The patient still very much wanted to proceed with surgery
Initial Procedure
- Dr. Weng started with the right eye and underwent 25-gauge PPV with endolaser and air fluid exchange
- The patient already had a full PVD, but when Dr. Weng was doing the shave one small peripheral tear occurred that was lasered and placed under air
- One week later, VA was 20/20 in the right eye with no floaters. The patient was thrilled and wanted to proceed with surgery for the left eye. Again, they discussed potential risks including RD, especially given the tear in the right eye and that he did not have a complete PVD in the left eye. Dr. Weng attempted to convince the patient to defer surgery, but he strongly desired PPV in the left eye
- Three weeks later, he underwent surgery in his left eye. Despite extreme care, a tear formed during hyaloid elevation, causing a tear with a small amount of localized subretinal fluid in the superior quadrant (Figure 1). Exercising caution, Dr. Weng tamponaded him under 20% sulphur hexafluoride (SF6) gas after lasering the tear
Postoperative Course
- His retina stayed attached, but his VA dropped to 20/80 very soon after surgery due to a rapidly progressing cataract
- Dr. Weng referred him to a cataract surgeon who performed uncomplicated phacoemulsification with a monofocal IOL in the left eye
- At postoperative month 1, the patient was thrilled with VA 20/20 in the left eye with no floaters
- At postoperative month 3, VA dropped to 20/200 in the left eye due to significant secondary epiretinal membrane (ERM) formation (Figures 2a and 2b)

Figure 2a. OCT following PPV, but prior to cataract surgery in the left eye. The image is hazy due to the cataract.
Figure 2b. OCT 3 months post-cataract surgery in the left eye. Significant distortion of all the underlying retinal layers is seen due to a secondary ERM.
Second Vitrectomy for Secondary ERM in Left Eye
- The patient underwent 25-gauge PPV with Kenalog and membrane peel in the left eye
- He had a prolonged recovery with slow resolution of retinal thickening (Figure 3)
- Six months post-ERM surgery in the left eye, VA was 20/30 with no floaters, but an irregular foveal contour remains
- Nevertheless, the patient was very happy and felt that his quality of life (QoL) had significantly improved. He said he would do it all again in spite of the sequence of events

Figure 3. OCT shows progressively reduced thickening of the macula following surgery for his secondary ERM over a 1-year period.
Clinical Pearls
1. PPV is relatively safe for vitreous opacities, but not without risks that must be discussed with patients, including:
- Retinal tear/detachment (reported risk ranges from 0-30% depending on hyaloid elevation1,2)
- Cataract formation/progression
- ERM
- Endophthalmitis
- Anesthesia-related issues
- Persistent/residual floaters
The panel was in consensus about the need to discuss the possibility of persistent floaters with patients. Dr. Weng uses the analogy of a peanut butter jar—you can never get all of the peanut butter out of the jar. Similarly, you can never get all of the vitreous out, especially if a surgeon is unable to elevate the hyaloid past a certain point, or some hyaloid is left in the retrolental anterior vitreous space.
2. Preoperative counseling is critical, especially if patients have a higher baseline risk for complications. This patient was much more understanding of the complications because he was educated about the potential risks before surgery
3. PPV for floaters can meaningfully improve patients’ QoL. In the literature, patients reported 69% improvement at postoperative month 3 in the modified Visual QoL questionnaire.3 Despite everything this patient went through, he was ultimately happy and had no regrets
1. Tan HS, Mura M, Lesnik Oberstein SY, Bijl HM. Safety of vitrectomy for floaters. Am J Ophthalmol. 2011;151(6):995-998.
2. Wa C, Yee K, Huang L, et al. Long-term safety of vitrectomy for patients with floaters. IOVS. 2013;54:2142.
3. Hahn U, Krummenauer F, Ludwig K. 23G pars plana vitrectomy for vitreal floaters: prospective assessment of subjective self-reported visual impairment and surgery-related risks during the course of treatment. Graefes Arch Clin Exp Ophthalmol. 2018;256(6):1089-1099.
Understanding the Potential Risks of Surgery for Vitreous Opacities
The panel was in consensus regarding patients with unrealistic expectations not being candidates for vitrectomy. Ultimately, if the risks outweigh the benefits, surgery is not warranted. Amongst the risks most discussed with patients, it was noted that risk of retinal tear can be high when the posterior hyaloid needs to be separated, but is considerably lower, if PVD is already present.16 The rate of postoperative RD has been reported within a range of 2.6% (consistent with Dr. Ryan’s experience) to 5.5%.3,18,19 With more conservative criteria (pseudophakic and complete PVD), Dr. Houston has found that the rate of RD decreases significantly, with an unpublished rate of 0.25% in the last 400 of his patients. These intra- and postoperative risks increase with the presence of an attached hyaloid and/or lattice, and a frank discussion of such risks with the patient is warranted.
Dr. Pollack noted that examination of the retinal periphery with scleral depression is an important step that should be performed at the end of every vitrectomy surgery, but particularly after vitrectomy for floaters since the incidence of retinal tears during these cases is higher than during vitrectomy for most other indications. The panel was in consensus that all surgeons should examine the periphery with scleral depression at the end of every case, especially following vitrectomies for vitreous opacities.
Dr. Houston and Dr. Kitchens do cutdown peribulbar blocks to avoid the potential risks associated with retrobulbar blocks such as muscle damage, inadvertent globe rupture, retrobulbar hemorrhage, and optic nerve injury. Dr. Weng, Dr. Ryan, and Dr. Pollack do retrobulbar blocks because any associated complication has been rare in their experiences.
Although it has been reported that cataract formation can be mitigated with limited vitrectomy (leaving a few millimeters of vitreous behind the lens),13 the panel wishes to see more data supporting the practice. Instead they focus on removing all of the symptomatic vitreous to reduce the risk of persistent floaters and advise the phakic patient that cataract progression should be anticipated.
Ultimately vitreoretinal surgery has never been safer. Over the past 2 decades, progress has included smaller gauge instruments, faster cut rates, and optimized fluidics. Vitrectomy still has risks but it remains the most effective option for symptomatic patients who seek a positive impact in their QoL from debilitating floaters.
Conclusions
Vitreous opacities are common and may represent a significant burden for patients that find them visually disabling.
A thorough history and ocular examination, combined with the SDM process, is the ideal approach to patients seeking management of their floaters. It is essential that patients have a clear understanding of the possible outcomes and potential complications.
This panel of surgeons is generally inclined to offer vitrectomy to patients with disabling floaters; however, the panel finds the future potential for office-based laser solutions interesting and would consider this option in the future, if supported by sufficiently compelling data.

WATCH NOW! A VITREOUS OPACITIES VIDEO CASE SERIES
Don’t miss these important case reviews from six leading experts.
1. Ivanova T, Jalil A, Antoniou Y, Bishop PN, Vallejo-Garcia JL, Patton N. Vitrectomy for primary symptomatic vitreous opacities: an evidence-based review. Eye (Lond). 2016;30(5):645-655.
2. Broadhead GK, Hong T, Chang AA. To Treat or Not to Treat: Management Options for Symptomatic Vitreous Floaters. Asia Pac J Ophthalmol (Phila). 2020;9(2):96-103.
3. Schulz-Key S, Carlsson JO, Crafoord S. Longterm follow-up of pars plana vitrectomy for vitreous floaters: complications, outcomes and patient satisfaction. Acta Ophthalmol. 2011;89(2):159-165.
4. Webb BF, Webb JR, Schroeder MC, North CS. Prevalence of vitreous floaters in a community sample of smartphone users. Int J Ophthalmol. 2013;6(3):402-405.
5. Bergstrom R, Czyz CN. Vitreous Floaters. [Updated 2020 May 21]. In: StatPearls [Internet]. Treasure Island (FL): StatPearls Publishing; 2020 Jan-. Available at: https://www.ncbi.nlm.nih.gov/books/NBK470420/?report=printabl.
6. Retina Health Series. Facts from the ASRS. Vitrectomy for Floaters. Available at: https://www.asrs.org/content/documents/fact-sheet-25-vitrectomy-for-floaters.pdf. Accessed September 9, 2020.
7. Wagle AM, Lim WY, Yap TP, Neelam K, Au Eong KG. Utility values associated with vitreous floaters. Am J Ophthalmol. 2011;152(1):60-65.
8. Shah CP, Fine HF. Management of Floaters. Ophthalmic Surgery, Lasers and Imaging Retina. 2018;49(6):388-391.
9. Schiff WM, Chang S, Mandava N, Barile GR. Pars plana vitrectomy for persistent, visually significant vitreous opacities. Retina. 2000;20(6):591-596.
10. Cohen MN, Rahimy E, Ho AC, Garg SJ. Management of Symptomatic Floaters: Current Attitudes, Beliefs, and Practices Among Vitreoretinal Surgeons. Ophthalmic Surg Lasers Imaging Retina. 2015;46(8):859-865.
11. Ryan EH, Lam LA, Pulido CM, Bennett SR, Calabrèse A. Reading Speed as an Objective Measure of Improvement Following Vitrectomy for Symptomatic Vitreous Opacities. Ophthalmic Surgery, Lasers and Imaging Retina. 2020;51(8):456-466.
12. Suñer IJ, Kokame GT, Yu E, Ward J, Dolan C, Bressler NM. Responsiveness of NEI VFQ-25 to changes in visual acuity in neovascular AMD: validation studies from two phase 3 clinical trials. Invest Ophthalmol Vis Sci. 2009;50(8):3629-3635.
13. Sebag J, Yee KMP, Nguyen JH, Nguyen-Cuu J. Long-Term Safety and Efficacy of Limited Vitrectomy for Vision Degrading Vitreopathy Resulting from Vitreous Floaters. Ophthalmol Retina. 2018;2(9):881-887.
14. Su D, Shah CP, Hsu J. Laser vitreolysis for symptomatic floaters is not yet ready for widespread adoption. Surv Ophthalmol. 2020;65(5):589-591.
15. Elwyn G, Laitner S, Coulter A, Walker E, Watson P, Thomson R. Implementing shared decision making in the NHS. BMJ. 2010;341:c5146.
16. Rahman R, Gormley J, Stephenson J. Risk of complications of vitrectomy for floaters based on attached or detached status of posterior hyaloid face. JVRD. 2018;2(1): 16-21.
17. Khoshnevis M, Rosen S, Sebag J. Asteroid hyalosis-a comprehensive review. Surv Ophthalmol. 2019;64(4):452-462.
18. Mason JO 3rd, Neimkin MG, Mason JO 4th, et al. Safety, efficacy, and quality of life following sutureless vitrectomy for symptomatic vitreous floaters. Retina. 2014;34(6):1055-61.
19. Rubino SM, Parke DW 3rd, Lum F. Return to the Operating Room after Vitrectomy for Vitreous Opacities: Intelligent Research in Sight Registry Analysis. Ophthalmol Retina. 2020:S2468-6530(20)30293-30301.












